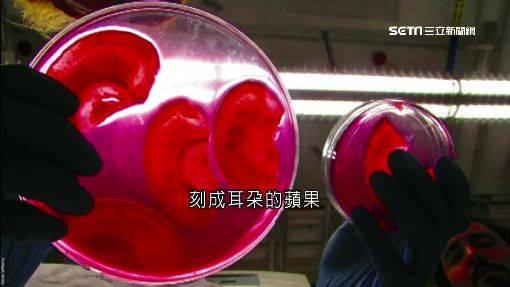

記者許嘉云/綜合報導
器官捐贈供需落差嚴重,直到今天,美國仍有超過十二萬人在等待器官捐贈,但培植技術時常伴隨著道德爭議,不過加拿大有一位生物學家成功避免這個問題,因為他用來培植器官的「母體」不是豬,也不是老鼠,而是一顆不到一美元的蘋果,利用細胞移植方法,先把蘋果雕出耳朵形狀,去除蘋果細胞和DNA,植入人類細胞,竟然真的「長出」一隻耳朵。
▲由蘋果培育出的人類耳朵。
剪頭髮遇上兩光理髮師,或被對手狠揍好幾拳,耳朵噴血差點掉下來。
體育主播:「這一拳血都噴出來了。」
耳朵再生技術來的正是時候!

▲加拿大生物學家安德魯。(圖/翻攝自TED)
加拿大生物學家安德魯:「我們隨手挑了一顆蘋果,移除所有的蘋果細胞和DNA,接著在上面植入人體細胞。」
把蘋果細胞換成耳朵細胞,利用蘋果的「纖維支架」讓人體細胞「攀附」而生,最後真的「長出」一隻耳朵。
加拿大生物學家安德魯:「我拜託我太太『請用蘋果幫我刻些耳朵』沒想到她真行,所以我們的實驗室有了些耳朵。」

▲切割成耳朵形狀的蘋果再生器官。(圖/翻攝自TED)
刻成耳朵的蘋果被植入人體細胞,培養成器官,不僅讓失聰者重獲新「聲」而且很便宜。
加拿大生物學家安德魯:「目前商業『纖維支架』很昂貴,而且問題很多,因為它們源自於專利產品、動物或屍體,但我們用的是蘋果,成本只有幾毛錢。」
生物學家安德魯的實驗室,不僅蘋果能生耳朵,還能借蘆筍培植血管、神經。

▲蘆筍培植人類血管/示意圖。
器官培植技術已經研究好幾十年,試驗品從動物變成蔬果,若能順利發展,將帶給外科醫學全新面貌。
